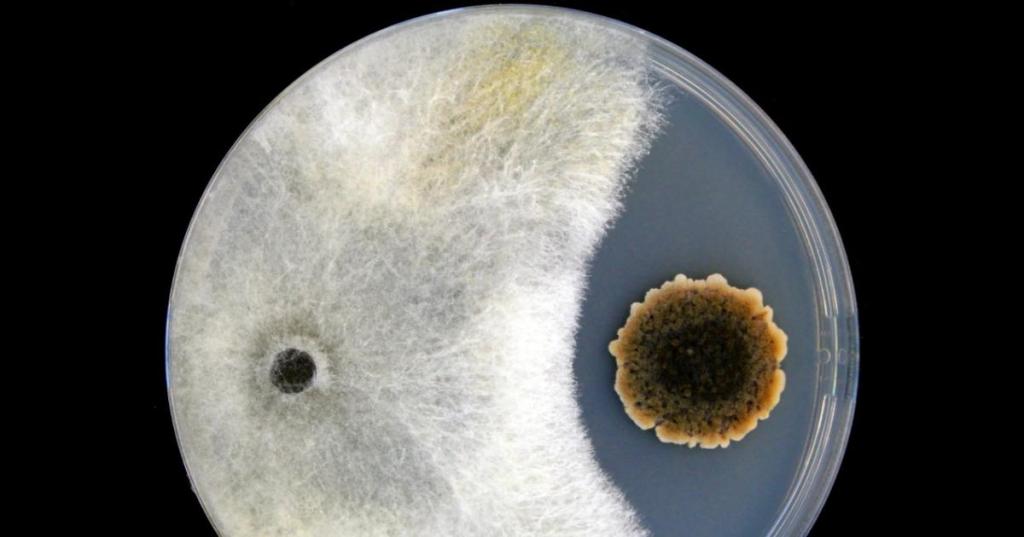

Especialistas Médicos del mundo aseguran que probablemente los hongos sean los responsables de una nueva pandemia
¡Compártelo!…¡El mundo es conocimiento!
- Comparte en Facebook (Se abre en una ventana nueva) Facebook
- Compartir en X (Se abre en una ventana nueva) X
- Compartir en Tumblr (Se abre en una ventana nueva) Tumblr
- Haz clic en Pinterest (Se abre en una ventana nueva) Pinterest
- Compartir en Reddit (Se abre en una ventana nueva) Reddit
- Compartir en LinkedIn (Se abre en una ventana nueva) LinkedIn
- Compartir en WhatsApp (Se abre en una ventana nueva) WhatsApp
- Compartir en Telegram (Se abre en una ventana nueva) Telegram
- Compartir en Mastodon (Se abre en una ventana nueva) Mastodon
- Enviar un enlace a un amigo por correo electrónico (Se abre en una ventana nueva) Correo electrónico
- Imprimir (Se abre en una ventana nueva) Imprimir

Deja un comentario